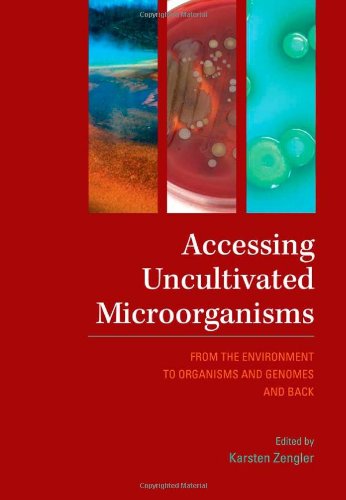
Book Image

production
/viewbook/list/all/?page=155
/
/static/
None

ACCESS CODE TO EBOOK&COURSEMATE
Not Available
Not available
Not available
Not available

Access Control, Authentication, and Public Key Infrastructure...
Bill Ballad
Jones & Bartlett Learning
Not available
0763791288
PART OF THE NEW JONES & BARTLETT LEARNING INFORMATION SYSTEMS SECURITY & ASSURANCE SERIES! Access control protects resources against... unauthorized viewing, tampering, or destruction. They serve as a primary means of ensuring privacy, confidentiality, and prevention of unauthorized disclosure. The first part of Access Control, Authentication, and Public Key Infrastructure defines the components of access control, provides a business framework for implementation, and discusses legal requirements that impact access control programs. It then looks at the risks, threats, and vulnerabilities prevalent in information systems and IT infrastructures and how to handle them. The final part is a resource for students and professionals which discusses putting access control systems to work as well as testing and managing them.

Access Controlled: The Shaping of Power, Rights, and Rule in...
Not Available
The MIT Press
Not available
0262514354
Internet filtering, censorship of Web content, and online surveillance are increasing in scale, scope, and sophistication around the world, in... democratic countries as well as in authoritarian states. The first generation of Internet controls consisted largely of building firewalls at key Internet gateways; China's famous "Great Firewall of China" is one of the first national Internet filtering systems. Today the new tools for Internet controls that are emerging go beyond mere denial of information. These new techniques, which aim to normalize (or even legalize) Internet control, include targeted viruses and the strategically timed deployment of distributed denial-of-service (DDoS) attacks, surveillance at key points of the Internet's infrastructure, take-down notices, stringent terms of usage policies, and national information shaping strategies. Access Controlled reports on this new normative terrain. The book, a project from the OpenNet Initiative (ONI), a collaboration of the Citizen Lab at the University of Toronto's Munk Centre for International Studies, Harvard's Berkman Center for Internet and Society, and the SecDev Group, offers six substantial chapters that analyze Internet control in both Western and Eastern Europe and a section of shorter regional reports and country profiles drawn from material gathered by the ONI around the world through a combination of technical interrogation and field research methods.

ACCESS + EXCEL 2010(BUNDLE) W/SAM 2010
Not Available
Not available
Not available
Not available

ACCESS HEALTH & TAKE CHARGE WKSHT
Not Available
Not available
Not available
Not available

Accessible Assessment: How 9 Sensible Techniques Can Power...
Michael F Opitz
Heinemann
Not available
0325030529
Count on the assessment that only counts what really counts With these nine sensible, essential assessments, teachers can gather all the data they... need. We share these assessments and show teachers how to use them across a school year for maximum instructional effect -Michael Opitz, Michael Ford, and James Erekson "Data-driven instruction" is a new education watchword. But today teachers don't have time to collect data about readers that isn't absolutely essential. Accessible Assessment simplifies reading instruction by only counting what really counts. Accessible Assessment isn't like many of today's complex, time-consuming assessment programs. It combines nine informal techniques into a manageable, calendarized framework that makes sense and drives highly targeted, differentiated instruction. Opitz, Ford, and Erekson help teachers: measure only what matters most assess with the confidence that comes from a strong research base increase consistency and organization across school years, grades, and buildings implement predictable assessment structures flexibly plan short-, medium-, and long-range instructional goals. Accessible Assessment can make a big difference for individual teachers, but it's even more powerful for teaching teams or entire buildings. It can bring a new level of coherence to any crucial assessment task, including: screening, progress monitoring, and diagnostics for RTI assessing for key reading standards (including Common Core) sharing information with colleagues, administrators, and parents. Make assessment count more than ever by counting only what really counts. Count on Accessible Assessment. Book study groups and professional learning communities, click here to save 15% when you order 15 copies of Accessible Assessment. A $330 value for $280.50-SAVE $49.50!

Accessible Golf: Making It a Game Fore All
Ladies Professional Golf Association
Human Kinetics
Not available
0880119799
Of all sport experiences, golf is ideal for people of all abilities. Its rules, strategies, facilities, and equipment can easily be adapted to... accommodate a wide range of individual needs. Accessible Golf addresses the specific aspects of building a full-participation golf program.This book contains details for making golf accessible within the guidelines of the Americans with Disabilities Act (ADA), taking into account the specific needs of your community and its individual members. Case studies and other practical, field-tested information allow you to fully understand the real-world needs of people with specific disabilities--including cognitive, attentional, visual, hearing, and physical impairments--and their implications for golf instruction. Developed by the Ladies' Professional Golf Association (LPGA), this comprehensive book offers all the tools to successfully implement an all-access program--from adapting equipment and environment to modifying instruction and details of play. Accessible Golf is the one resource golf instructors, club owners, and people who have disabilities or work with someone who has a disability will use to reap the benefits of this popular game.

Accessible Mathematics: Ten Instructional Shifts That Raise Student...
Steven Leinwand
Heinemann
Not available
0325026564
Raising students' math achievement doesn't mean ripping up your planning book and starting over. In Accessible Mathematics Steven Leinwand (author of... Sensible Mathematics) shows how small shifts in the good teaching you already do can make a big difference in student learning. Steve focuses on the crucial issue of classroom instruction. He scours the research and visits highly effective classrooms for practical examples of small adjustments to your teaching that lead to deeper student learning in math. Some of his 10 classroom-tested teaching shifts may surprise you and others will validate your thinking. But all of them will improve your students' performance. Thoroughly practical and ever-aware of the limits of teachers' time, Steve gives you everything you need to put his commonsense ideas to use immediately. His extensive planning advice will help you streamline your teaching to get more from everything you do. Classroom examples from every grade level model teaching language and instructional moves. And his suggestions for professional learning help increase your effectiveness through the power of collaboration. Steven Leinwand shares your priority: raising the mathematical understanding and achievement of every one of your students. Read Accessible Mathematics, try his 10 suggestions in your practice, and discover how minor shifts in your teaching can put student learning into high gear.

ACCESSIBLE READINGS IN SOCIOLOGY
Not Available
Not available
Not available
Not available

Accessing the General Curriculum: Including Students With...
Not Available
Corwin Press
Not available
1412916496
Featuring updated strategies for fitting special education into frameworks created by standards and assessments, this indispensable resource shows... teachers how to achieve expected results with all students.

Accessing the Superintendency: The Unwritten Rules (1-Off Series)
Marilyn Tallerico
Corwin Press
Not available
0803968965
Pursuing and obtaining a superintendency is more complicated than any other educational employment process. Research-based and very practical, this... insiders' view shows how to overcome the invisible selection criteria, the unwritten rules, and the biases that often shut out qualified women and racially and ethnically diverse candidates.

Accessing the WAN, CCNA Exploration Companion Guide
Bob Vachon
Cisco Press
Not available
1587132052
Accessing the WAN CCNA Exploration Companion Guide Bob Vachon Rick Graziani Accessing the WAN, CCNA Exploration Companion Guide is the... official supplemental textbook for the Accessing the WAN course in the Cisco Networking Academy CCNA Exploration curriculum version 4. This course discusses the WAN technologies and network services required by converged applications in enterprise networks. The Companion Guide, written and edited by Networking Academy instructors, is designed as a portable desk reference to use anytime, anywhere. The book’s features reinforce the material in the course to help you focus on important concepts and organize your study time for exams. New and improved features help you study and succeed in this course: Chapter objectives: Review core concepts by answering the focus questions listed at the beginning of each chapter. Key terms: Refer to the updated lists of networking vocabulary introduced and turn to the highlighted terms in context in each chapter. Glossary: Consult the all-new comprehensive glossary with more than 250 terms. Check Your Understanding questions and answer key: Evaluate your readiness with the updated end-of-chapter questions that match the style of questions you see on the online course quizzes. The answer key explains each answer. Challenge questions and activities: Strive to ace more challenging review questions and activities designed to prepare you for the complex styles of questions you might see on the CCNA exam. The answer key explains each answer. Bob Vachon is the coordinator of the Computer Systems Technology program and teaches networking infrastructure courses at Cambrian College in Sudbury, Ontario, Canada. Bob has worked and taught in the computer networking and information technology field for 25 years and is a scholar graduate of Cambrian College. Rick Graziani teaches computer science and computer networking courses at Cabrillo College in Aptos, California. Rick has worked and taught in the computer networking and information technology field for 30 years. How To: Look for this icon to study the steps that you need to learn to perform certain tasks. Packet Tracer Activities: Explore networking concepts in activities interspersed throughout some chapters using Packet Tracer v4.1 developed by Cisco. The files for these activities are on the accompanying CD-ROM. Also available for the Accessing the WAN Course Accessing the WAN, CCNA Exploration Labs and Study Guide ISBN-10: 1-58713-201-X ISBN-13: 978-1-58713-201-8 Companion CD-ROM The CD-ROM provides many useful tools and information to support your education: Packet Tracer Activity exercise files A Guide to Using a Networker’s Journal booklet Taking Notes: A .txt file of the chapter objectives More IT Career Information Tips on Lifelong Learning in Networking This book is part of the Cisco Networking Academy Series from Cisco Press. The products in this series support and complement the Cisco Networking Academy online curriculum.

Accessing the WAN: CCNA Exploration Companion Guide
Bob Vachon
Cisco Press
Not available
1587133490
Each new purchase of an Exploration Companion guide comes with an exclusive coupon code that can be used to Save 65% on these two additional study... resources: 1. CCNA ICND2 640-822 Official Cert Guide, Premium Edition eBook and Practice Test (www.ciscopress.com/title/0132903806) 2. Accessing the WAN Companion Guide eBook (www.ciscopress.com/title/0132877589) Accessing the WAN, CCNA Exploration Companion Guide is the official supplemental textbook for the Accessing the WAN course in the Cisco Networking Academy CCNA Exploration curriculum version 4. This course discusses the WAN technologies and network services required by converged applications in enterprise networks. The Companion Guide, written and edited by Networking Academy instructors, is designed as a portable desk reference to use anytime, anywhere. The book’s features reinforce the material in the course to help you focus on important concepts and organize your study time for exams. New and improved features help you study and succeed in this course: Chapter objectives: Review core concepts by answering the focus questions listed at the beginning of each chapter. Key terms: Refer to the updated lists of networking vocabulary introduced and turn to the highlighted terms in context in each chapter. Glossary: Consult the all-new comprehensive glossary with more than 250 terms. Check Your Understanding questions and answer key: Evaluate your readiness with the updated end-of-chapter questions that match the style of questions you see on the online course quizzes. The answer key explains each answer. Challenge questions and activities: Strive to ace more challenging review questions and activities designed to prepare you for the complex styles of questions you might see on the CCNA exam. The answer key explains each answer. Bob Vachon is the coordinator of the Computer Systems Technology program and teaches networking infrastructure courses at Cambrian College in Sudbury, Ontario, Canada. Bob has worked and taught in the computer networking and information technology field for 25 years and is a scholar graduate of Cambrian College. Rick Graziani teaches computer science and computer networking courses at Cabrillo College in Aptos, California. Rick has worked and taught in the computer networking and information technology field for 30 years. How To: Look for this icon to study the steps that you need to learn to perform certain tasks. Packet Tracer Activities: Explore networking concepts in activities interspersed throughout some chapters using Packet Tracer v4.1 developed by Cisco. The files for these activities are on the accompanying CD-ROM. Also available for the Accessing the WAN Course Accessing the WAN, CCNA Exploration Labs and Study Guide ISBN-10: 1-58713-201-X ISBN-13: 978-1-58713-201-8 Companion CD-ROM The CD-ROM provides many useful tools and information to support your education: Packet Tracer Activity exercise files A Guide to Using a Networker’s Journal booklet Taking Notes: A .txt file of the chapter objectives More IT Career Information Tips on Lifelong Learning in Networking This book is part of the Cisco Networking Academy Series from Cisco Press. The products in this series support and complement the Cisco Networking Academy online curriculum.

Accessing the WAN, CCNA Exploration Labs and Study Guide
John Rullan
Cisco Press
Not available
158713201X
Accessing the WAN CCNA Exploration Labs and Study Guide John Rullan Accessing the WAN, CCNA Exploration Labs and Study Guide is designed to... support your learning the technologies and network services required by converged applications as taught in Version 4 of the Cisco® Networking Academy® CCNA® Exploration curriculum. Each chapter contains a Study Guide section and a Labs and Activities section. Study Guide The dozens of exercises in this book help you learn the concepts and configurations crucial to your success as a CCNA exam candidate. Each chapter is slightly different and includes multiple-choice, fill-in-the-blank, and open-ended questions designed to help you Review vocabulary Strengthen troubleshooting skills Boost configuration skills Reinforce concepts Research topics Labs and Activities The Labs and Activities sections include all the online curriculum labs plus some additional activities to ensure that you have mastered the practical skills needed to succeed in this course. Hands-On Labs–This icon identifies the hands-on labs created for each chapter. Work through all the Basic, Challenge, and Troubleshooting labs to gain a deep understanding of the CCNA knowledge and skills needed to ultimately succeed on the CCNA Certification Exam. Packet Tracer Activities–This icon identifies exercises created by the author for you to challenge yourself on specific tasks using Packet Tracer, a powerful network simulation program developed by Cisco. Packet Tracer Companion–This icon identifies the companion activities that correspond to each hands-on lab. You'll use the Packet Tracer to complete a simulation of the hands-on lab. Packet Tracer Skills Integration Challenge–Each chapter concludes with a culminating activity called the Packet Tracer Skills Integration Challenge. These challenging activities require you to combine several skills learned from the chapter–as well as previous chapters and courses–to successfully complete one comprehensive exercise. John Rullan has been a Cisco Instructor since 1998. He teaches CCNA, CCNP®, and network security courses to students and teachers throughout the New York City Department of Education system. Use this book with: Accessing the WAN, CCNA Exploration Companion Guide ISBN-10: 1-58713-205-2 ISBN-13: 978-158713-205-6 Companion CD-ROM The CD-ROM provides all the Packet Tracer Activity, Packet Tracer Companion, and Packet Tracer Challenge files that are referenced throughout the book as indicated by the icons. These files work with Packet Tracer software v4.1, which is available through the Academy Connection website. Ask your instructor for access to the Packet Tracer software. This book is part of the Cisco Networking Academy Series from Cisco Press®. Books in this series support and complement the Cisco Networking Academy curriculum.
Accessing Uncultivated Microorganisms: From the Environment to...
Karsten Zengler
ASM Press
Not available
1555814069
* Provides a comprehensive overview and discusses the latest developments in the field * Details various innovative methods for assessment of microbes... both within and outside of the laboratory * Reviews many different methods used in microbial ecology and environmental microbiology * Presents chapters authored by world-renowned experts in the field * Highlights various aspects of assessing microorganism from the environment * Includes all aspects of microbial diversity from bacteria and fungi to protists * Presents a crucial "how to" guide for isolating organisms from different environments
 '
'





